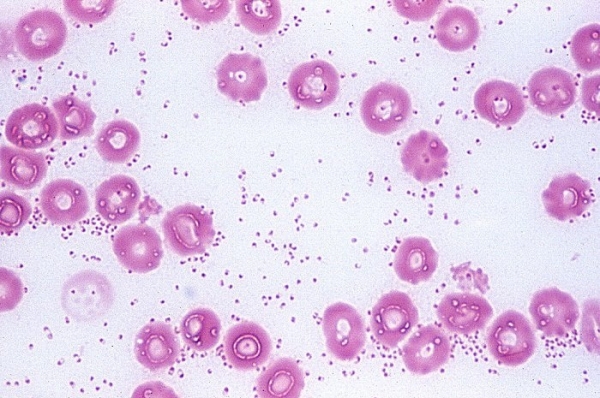

Из-за массового применения химиопрепаратов, плохой экологии, а также вакцинации список инфекционных заболеваний резко переменился. Серьезную опасность в птицеводстве представляют заболевания, которые распространяются вследствие нарушений в содержании птиц. Одной из таких болезней является пастереллез у кур. Какие бывают симптомы этой болезни, как происходит лечение домашних пернатых? Узнайте вместе с нами.
Причины болезни
P. Multocida и P. Haemolytica – главные причины возникновения хвори. Пастереллез возникает именно из-за этих Пастерелл – палочек, которые имеют эллипсовидную форму. Они располагаются в изоляции и не образуют спор. Свежевыделенный штамм имеет капсулу. В мазках с органов и крови пастереллез имеет вид овоида, в культурах – диплококка.

Форма и величина этих бактерий может варьироваться от происхождения штамма. В естественной среде Пастерелла попадает в организм животного алиментарными и респираторными путями. Очень редко может попасть туда через ранку. Далее бактерия начинает размножаться, проникает в кровь и лимфу, что провоцирует летальный исход птицы приблизительно через двенадцать – тридцать шесть часов.
Бактерия подавляет генерализацию процесса фагоцитоза, что влечет за собой массовое повреждение ею капилляров. В итоге появляются большие отеки в межмышечной клетчатке и геморрагический диатез. Летальность и заболеваемость пастереллезом у кур сильно варьируются. Все зависит от того, как вирулентен возбудитель и правильны ли условия кормления и содержания кур.
Симптомы
Инкубационный период пастереллеза у кур может колебаться от пары часов до двух суток. Это заболевание может протекать подостро, остро, сверхостро и хронически. Птица становится угнетенной, проявляется вялость, гипертермия, которая доходит до 39º по Цельсию, и анорексия. Начало заболевания может характеризоваться замедлением дефекации, каловые отходы становятся водянистыми, иногда с примесью крови. Иногда проявляются и такие симптомы, как кровавая моча, конъюнктивит и проявление кровянистых носовых истечений.

В случае кишечной формы заболевания, пастереллез у кур может спровоцировать серьезное поражение ЖКТ. В этом случае сохраняется хороший аппетит, однако птица угнетена, может развиваться анемия. При хроническом пастереллезе у кур обнаруживается нарушение дыхания и пищеварения, в отличие от кишечной формы. Но возникает диарея, которая, в свою очередь, приводит к кахексии и истощению.
Сверхострое течение пастереллеза у кур отмечается в начале эпизоотии. Птица может неожиданно упасть, несколько раз взмахнуть крылышками и погибнуть без каких-либо симптомов заболевания. Куры становятся вялыми, крылья их опускаются, температура тела может повыситься до 43º С и выше. Из носового отверстия появляется слизь, похожая на пену. Дыхание у куриц напряженное, могут проявляться влажные хрипы, птица гибнет в судорогах.
В случае подострого течения хвори могут проявляться такие симптомы, как малокровие, воспаление суставов, истощение. У некоторых особей может наблюдаться припухание гиц сережек, затем они становятся плотными, появляется некроз.

Лечение
По правилам ветеринарного союза, а также санитарно-эпидемиологической станции лечение пастереллеза у кур запрещено. Как правило, лечение не производят, зараженных особей уничтожают, чтобы остальная стая не заразилась. Связано это и с тем, что пастереллез у кур при его лечении крайне часто переходит в хроническую форму. Следовательно, больная птица – длительный переносчик заразы.
Но можно сделать несколько попыток спасти больного пернатого, если болезнь еще на первой стадии, при помощи раствора норсульфазола или тетрациклина. Однако лечение пастереллеза у кур дело довольно сложное и лучше эту хворь предупредить. Профилактика состоит в должном соблюдении норм санитарии, а также в предохранительных прививках и иммуномоделирующих препаратах. Необходимо тщательно дезинфицировать птичник, место для выгула и весь инвентарь для работы.

В птицеводческом хозяйстве для предупредительного лечения этой хвори ветеринары рекомендуют использование сухой живой вакцины, которые были изготовлены из пастеровского авирулентного штамма. Живой вакциной следует прививать птиц в хозяйствах, где была обнаружена острая вспышка. При этом проводится строгая выбраковка всех больных птиц. К пятому дню формируется иммунитет к пастереллезу, который затем сохраняется до полугода.
Видео «О пастереллезе кур»
В следующем видео можно узнать о пастереллезе у кур, а также, что делать, если на птицеферме появились симптомы этого ужасного заболевания.